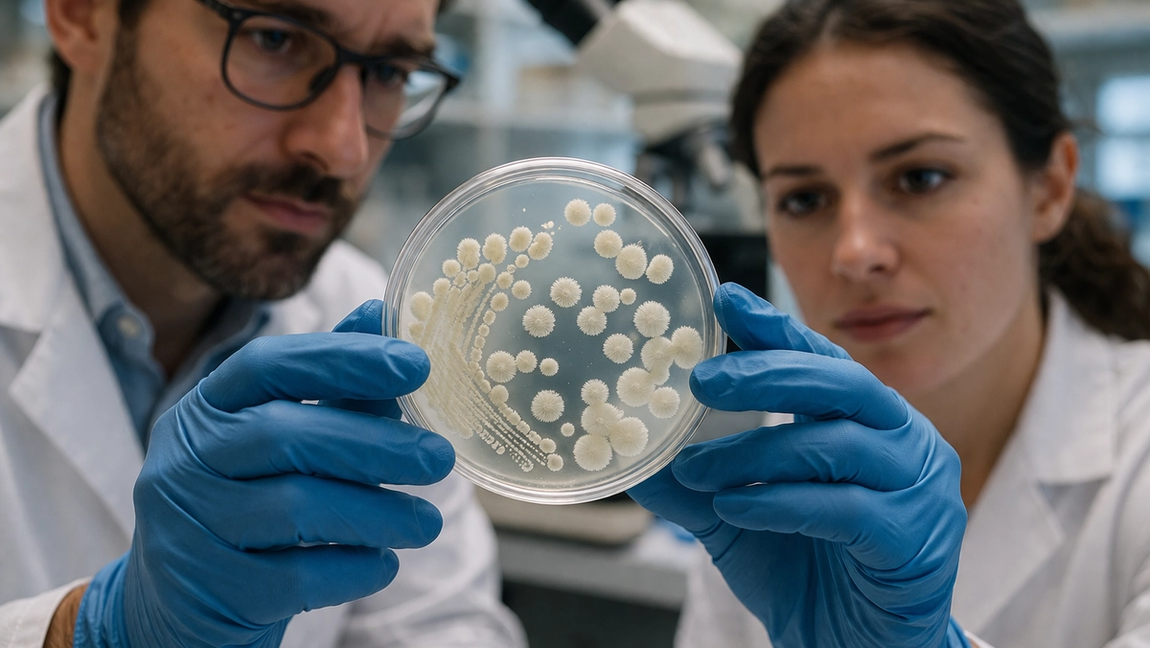
Scientists Found the Real Reason Probiotics Work, And It’s Not What You Think
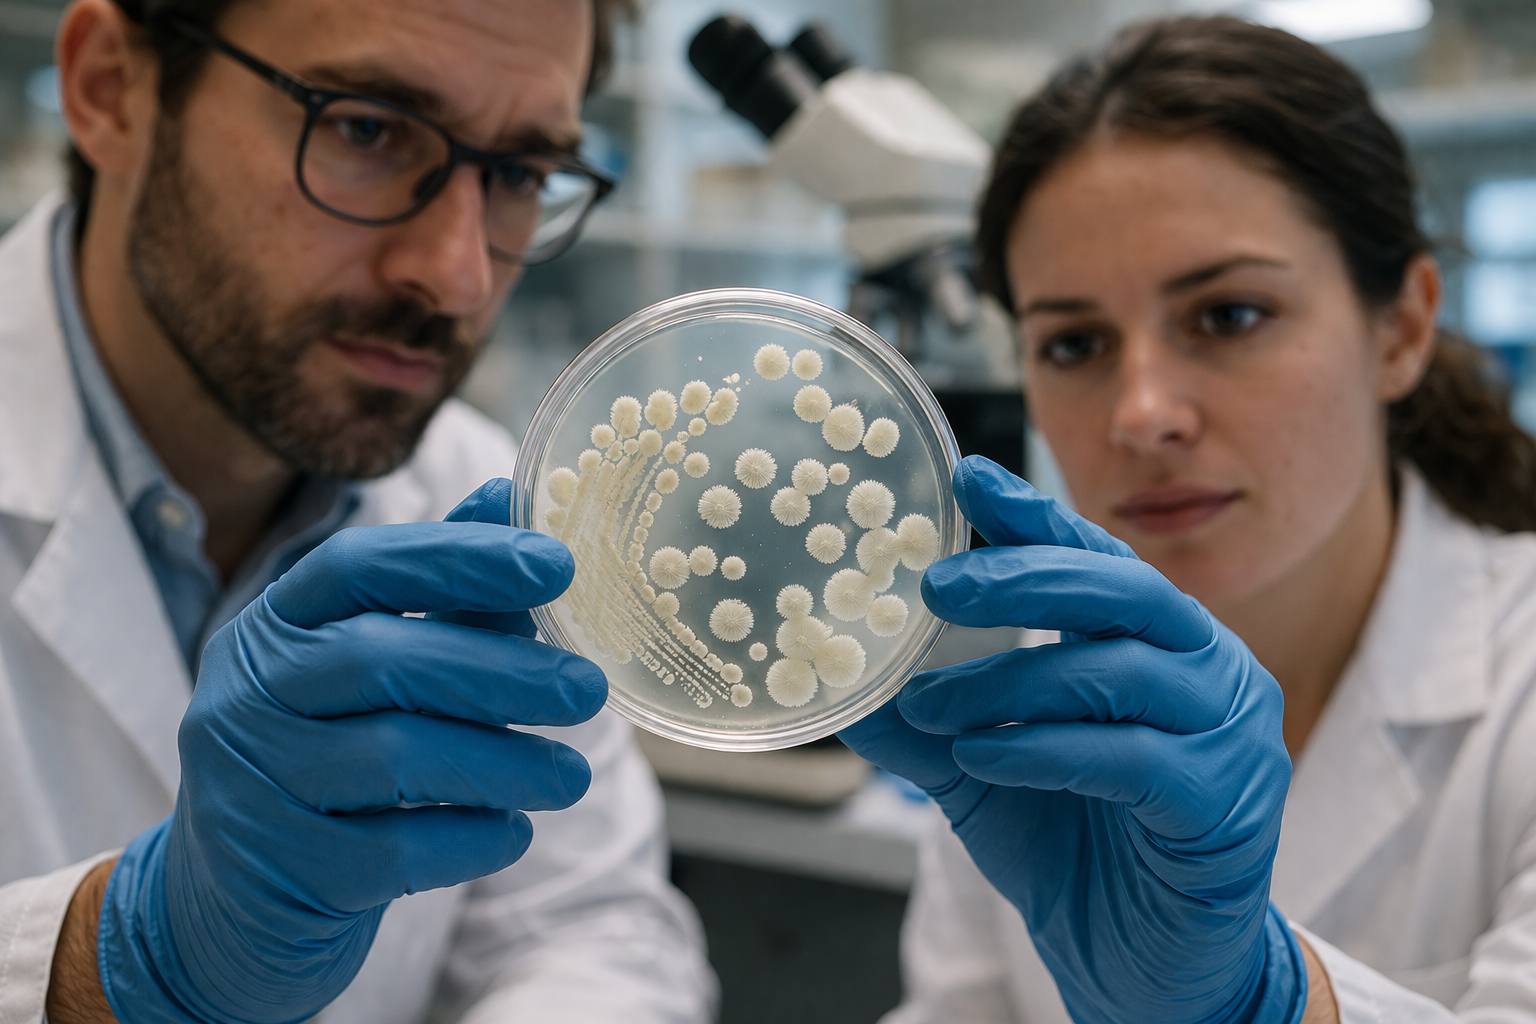

Scientists Found the Real Reason Probiotics Work, And It’s Not What You Think
By Kate Willis on December 18, 2025
For years, probiotics have been marketed with a simple message: add more “good bacteria” to your gut, and your digestion will improve. It sounds logical, and to some extent, it’s true. But recent research suggests that this explanation barely scratches the surface.
It’s Less About Colonization, More About Communication
One of the biggest misconceptions is that probiotics permanently “move in” and take over your gut. In reality, many probiotic strains don’t stay long-term. They pass through your system within days or weeks.
So why do they still work?
Because while they’re there, they interact with your body in powerful ways. Scientists now believe probiotics act more like messengers than permanent residents. They send signals to your gut, your immune system, and even your nervous system.
These signals can influence how your body responds to food, inflammation, and harmful bacteria.
They Train Your Immune System
Your gut is home to a large portion of your immune system. When probiotics enter your digestive tract, they don’t just sit there. They engage with immune cells and help regulate how your body reacts to potential threats.
Instead of simply “fighting bad bacteria,” probiotics help your immune system learn when to respond and when to stay calm. This balance is crucial. An overactive immune response can lead to inflammation, while an underactive one leaves you vulnerable.
In this way, probiotics act more like trainers than warriors.
They Strengthen Your Gut Barrier
Another key function of probiotics is supporting the gut lining. Your intestinal wall acts as a barrier, controlling what enters your bloodstream.
When this barrier is compromised, unwanted particles can pass through, leading to discomfort and inflammation. Certain probiotic strains help reinforce this barrier by supporting the cells that line your gut.
This is one of the reasons people often report feeling less bloated or sensitive after consistent probiotic use.
They Influence Your Gut Environment
Probiotics also change the environment inside your gut in subtle but important ways. They can produce compounds like short-chain fatty acids, which help nourish the cells in your digestive system.
They also compete with harmful bacteria for space and resources, making it harder for unwanted microbes to thrive.
So instead of simply adding more bacteria, probiotics help create conditions where beneficial bacteria can flourish naturally.
Why Not All Probiotics Feel the Same
If probiotics are about interaction rather than just presence, then the type of strains you take matters more than ever.
Different strains send different signals, support different functions, and produce different effects. This is why some probiotics feel more effective than others.
A well-formulated probiotic focuses not only on the number of bacteria, but also on how those strains work together and how they interact with your body.
That is part of the reason newer formulations have started moving toward more comprehensive approaches. For example, Flora Biome™ Live Probiotic is designed as a 3-in-1 formula that supports digestion, helps reduce discomfort, and promotes long-term gut balance. Instead of focusing on a single outcome, it reflects the idea that gut health is interconnected.
It’s Not About “Fixing” Your Gut Overnight
The idea of probiotics as a quick fix is another myth that science is slowly moving away from. Because their effects are based on interaction and signaling, results tend to build over time.
You might notice small changes at first, like improved digestion or less bloating. Over time, these changes can become more consistent as your gut environment stabilizes.
This is why consistency matters more than intensity. Taking a well-designed probiotic regularly allows these interactions to happen again and again, reinforcing their effects.
A Shift in How We Understand Gut Health
The biggest takeaway from recent research is this: probiotics are not just about adding something new to your body. They are about influencing systems that are already there.
They communicate, regulate, and support.
And once you understand that, it changes how you choose and use them. It becomes less about chasing the highest numbers on a label and more about finding a product that works with your body in a meaningful way.
Because in the end, the real power of probiotics is not in how many bacteria they contain, but in how intelligently they interact with you.
Disclaimer: This content is for informational purposes only and should not replace professional medical advice.










